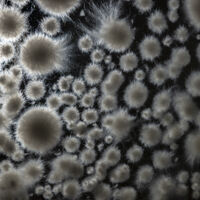

Studierende des Fachbereichs Design und der Peter Behrens School of Arts der Hochschule Düsseldorf wurde im Labor für Lebensmittelbiotechnologie des Fachbereichs Oecotrophologie der Hochschule Niederrhein eindrucksvoll verdeutlicht, wie fruchtbar die Zusammenarbeit zwischen Wissenschaftler:innen und Gestalter:innen von Beginn an sein kann. Unter der Leitung von Professorin Miriam Sari und ihrem Team erhielten 21 Studierende eine fundierte und praxktische Einführung in die Mykologie.
Dies geschah im Rahmen der Kurse „Pilz und Porzellan" sowie „Fungi_Future" von Professorin Lisa Freyschmidt. In diesen Kursen steht die interdisziplinäre Erforschung und Gestaltung im Spannungsfeld zwischen Pilzen, Keramik und Produktgestaltung im Mittelpunkt.
Begleitet wird die Kooperation von einem Expertenpool aus den Bereichen Wissenschaft, Design und Kulinarik.